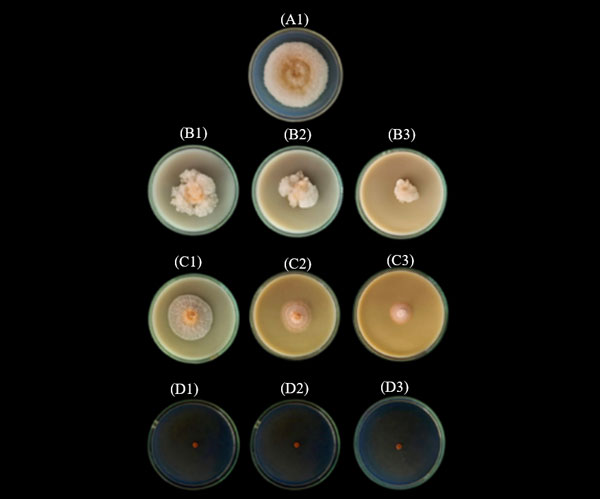

Songklanakarin Journal of Science and Technology (SJST)
Volume 46 No.5 (September - October 2024)
pp. 398 - 483
Exploring responsible tourism management in tour operators
Patakorn Kaewmorakot, Patakorn Kaewmorakot, Nontipak Pianroj, Nontipak Pianroj, Prachyakorn Chaiyakot and Prachyakorn Chaiyakot

Optimization of rice syrup production by solid-state fermentation using Aspergillus tamarii
Chanthana Chanchomsuk, Chanthana Chanchomsuk, Kamonlak Wicharaew, Kamonlak Wicharaew, Kanok-orn Srimuang, Kanok-orn Srimuang, Trakul Prommajak, Trakul Prommajak, Ratana Attabhanyo and Ratana Attabhanyo

Development of rice porridge for elderly with dysphagia
Pakanun Charoensri and Kongkarn Kijroongrojana

Identifying and evaluating the key impact factors of selecting formwork in high-rise building construction
Vu Hong Son Pham, Thuy Dung Dau and Le Anh Tran

Effects of seed pelleting with fungicide on seed quality and inhibition of Fusarium sp. in Chili (Capsicum annuum L.)
Jakkrapong Kangsopa, Aranya Singsopa, Nararat Thawong, Sukanya Baomeesri, Davika Rapeebunyanon and Sirikorn Charoenyai
Orthopairian fuzzy similarity based on below, above and centre fuzzy sets with applications to pattern recognition and identification of best ISP
Zahid Hussain, Yasmeen Bano, Sahar Abbas, Rashid Hussain and Muhammad Alam
Impact of agricultural infrastructure and government support on farmers’ welfare in Indonesia
Imade Yoga Prasada, Ayu Putri Merry Anisya and Agus Dwi Nugroho

Analysis of shoreline change along the coast of Rembang, Indonesia, using digital shoreline analysis system
Alfa Bagas Putra Trinida, Max Rudolf Muskananfola, Sigit Febrianto and Diah Ayuningrum


Analysis of physicochemical properties, trihalomethane levels, and trihalomethane formation potential in Cagayan de Oro city's primary drinking water source
Ronnie L. Besagas, Romeo M. Del Rosario and Angelo Mark P. Walag








